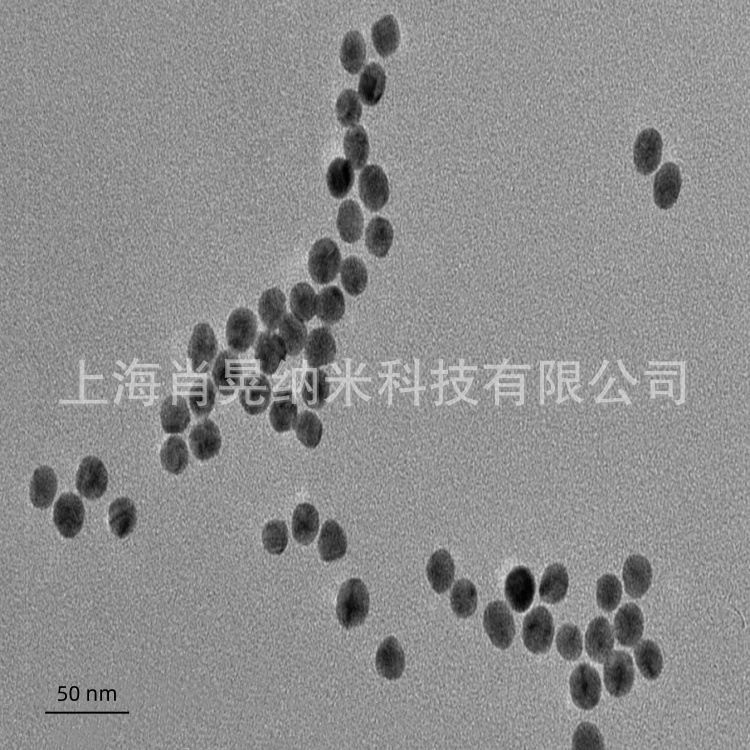

|





| 产地 | 上海 |
| 品牌 | 肖晃纳米 |
| 货号 | XH-SiO2-15 |
| 用途 | 用于陶瓷、纳米陶瓷、复合陶瓷基片 |
| 包装规格 | 100g/500g/1kg/5kg |
| CAS编号 | |
| 纯度 | 99.9-99.999% |
| 是否进口 | 否 |
产品介绍:
产品特点:
1、产品纯度高,粒径小,分布均匀,比表面积大,高表面活性,耐高温,松装密度低;
2、产品具有良好的分散性、悬浮性、振动液化性;和很好的触变性以及很好的补强和增稠作用;经过表面处理有更好的亲水和亲油性;
3、表面存在大量的不饱和残键及不同键合状态的羟基,因表面欠氧而偏离了稳定的硅氧结构,所以具有高反应活性,粉体松装密度比较小,容易分散使用;
4、对紫外光和可见光都呈现较高的反射特性。对紫外短波(200~280nm)的反射率达70%~80%;对紫外中长波(280~400nm)的反射率达80%~85%;对可见光(400~800nm)的反射率达85%以上;对800~1350波段的近红外线的反射率也达70%以上。
产品参数:
| 产品归类 | 货号 | 平均粒径 | 纯度(%) | 形貌 | 颜色 |
| 纳米级 | XH-SiO2-15 | 15nm | >99.9 | 球形 | 白色 |
| 纳米级 | XH-SiO2-30 | 30nm | >99.9 | 球形 | 白色 |
| 纳米级 | XH-SiO2-50 | 50nm | >99.9 | 球形 | 白色 |
| 纳米级 | XH-SiO2-100 | 100nm | >99.9 | 球形 | 白色 |
| 亚微米级 | XH-SiO2-300 | 300nm | >99.9 | 球形 | 白色 |
| 亚微米级 | XH-SiO2-500 | 500nm | >99.9 | 球形/非球形 | 白色 |
| 亚微米级 | XH-SiO2-800 | 800nm | >99.9 | 球形/非球形 | 白色 |
| 微米级 | XH-SiO2-001 | 1um | >99.9 | 球形/非球形 | 白色 |
| 微米级 | XH-SiO2-003 | 3um | >99.9 | 球形/非球形 | 白色 |
| 微米级 | XH-SiO2-005 | 5um | >99.9 | 球形/非球形 | 白色 |
| 微米级 | XH-SiO2-010 | 10um | >99.9 | 球形/非球形 | 白色 |
| 微米级 | XH-SiO2-020 | 20um | >99.9 | 球形/非球形 | 白色 |
| 微米级 | XH-SiO2-030 | 30um | >99.9 | 球形/非球形 | 白色 |
| 本公司可根据客户要求提供不同粒径和纯度的微纳米粉体定制生产 | |||||
产品应用:
1、橡胶改性、密封胶陶瓷增韧、黏结剂改性、功能纤维添加剂、塑料改性、抗油漆老化添加剂;
2、陶瓷、纳米陶瓷、复合陶瓷基片;
3、聚合物:可增加聚合物的热稳定性和抗老化性;
4、阻燃材料,涂料、高级研磨介质、化妆品等产品;
5、在传统涂料中添加少量纳米氧化硅后,很好的解决了其悬浮稳定性差、触变性差、抗老化性差、光洁度不高等问题。
产品包装:
本品为充惰气包装,密封保存于干燥、阴凉的环境中,不宜暴露空气中,防受潮发生氧化团聚,影响分散性能和使用效果;包装数量可以根据客户要求提供,分装。

返回顶部